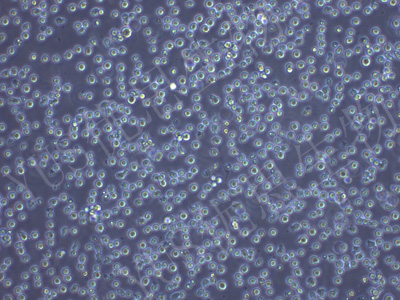

产品中心
产品中心
-

ProPakA.6 人胚肾细胞(STR鉴定)
货号:YLH198规格: 1*10^6 -

LOVO 人结肠癌细胞(STR鉴定)
货号:YLH199规格: 1*10^6 -

U-138 MG 人脑星形胶质母细胞瘤(STR鉴定)
货号:YLH201规格: 1*10^6 -

KTC-1 人甲状腺癌细胞(STR鉴定)
货号:YLH202规格: 1*10^6 -

NCI-H3122 人非小细胞肺癌细胞(STR鉴定)
货号:YLH203规格: 1*10^6 -

HCE-T 人角膜上皮细胞(STR鉴定)
货号:YLH204规格: 1*10^6 -
MEG-01 人成巨核细胞白血病细胞(STR鉴定)
货号:YLH206规格: 1*10^6 -

SW982 人滑膜肉瘤细胞(STR鉴定)
货号:YLH207规格: 1*10^6 -

A2780 人卵巢癌细胞(STR鉴定)
货号:YLH208规格: 1*10^6 -

hccc-9810 人胆管细胞型肝癌细胞(STR鉴定)
货号:YLH209规格: 1*10^6 -

RL95-2 人子宫内膜癌细胞(STR鉴定)
货号:YLH210规格: 1*10^6 -

OS-RC-2 人肾癌细胞(STR鉴定)
货号:YLH211规格: 1*10^6
在线咨询
Online consultation

关注微信公众号


